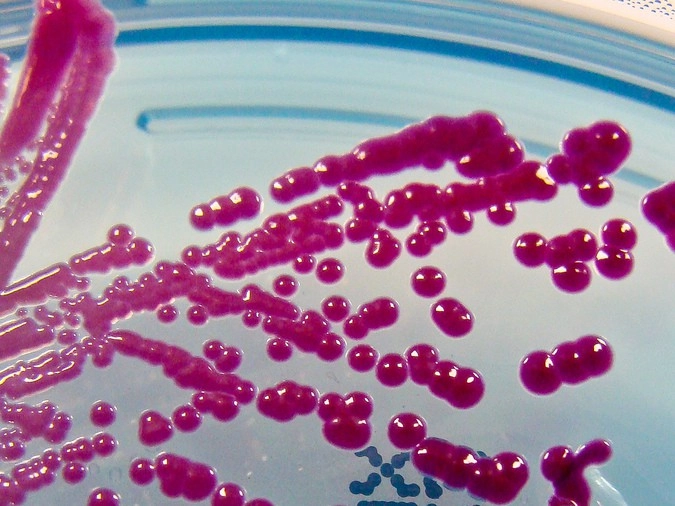

Создан смартфон с детектором инфекционных заболеваний
- 23 октября 2017 13:58
- Эрика Ефремова, журналист «Ридуса», отдел «Наука и технологии»
Команда ученых из американских институтов создала новую платформу для диагностики инфекционных заболеваний. Как отмечают разработчики, это первое в мире мини-устройство, способное определять вирусные заболевания всего за 30 минут по одной капле крови или другой жидкости.
Система состоит из обычного смартфона без всяких модификаций и напечатанной на 3D-принтере микрофлюидальной карты с оптическими и электрическими элементами, которая взаимодействует с основной камерой телефона.
Устройство удобно тем, что всего за одно взятие крови оно может определить наличие более чем одного патогена. Это позволяет диагностировать ряд возбудителей со схожими симптомами, а также существенно экономит время и деньги пациента.
Это будущее медицины — передовая линия профессиональных медиков. Мы не можем остановить вирусы и бактерии, но можем диагностировать их быстрее, поделился Дэвид Нэш, один из участников проекта.
Аппарат уже тестировали на лошадях, и он смог определить наличие четырех респираторных заболеваний у животных. С участием людей опыты тоже проводились, и система успешно справилась с диагностикой вирусов Денга, Зика и Чикунгунья.
Разработчики аппарата уверены, что их система станет незаменимой, так как может использоваться в регионах, где недоступна быстрая медицинская помощь, а также будет необходима в тех случаях, когда нужно срочно сдать анализ.
Дэвид Нэш заявил, что уже в скором времени его команда начнет тестирование аппарата в разных уголках нашей планеты, после чего устройство запустят в массовое производство по доступной цене.
- Телеграм
- Дзен
- Подписывайтесь на наши каналы и первыми узнавайте о главных новостях и важнейших событиях дня.

Войти через социальные сети: